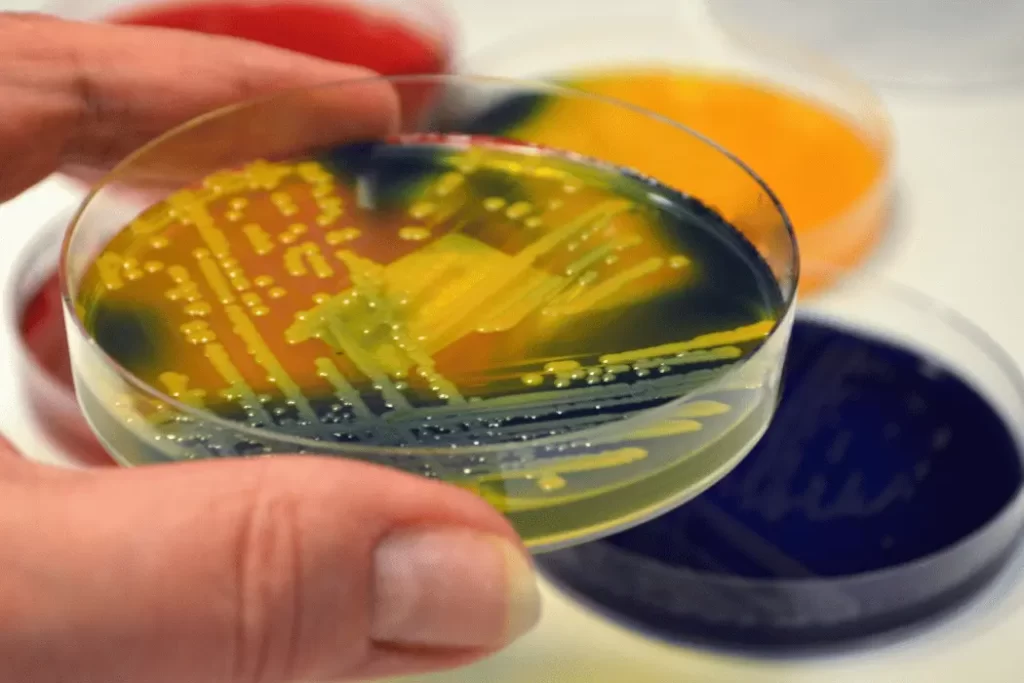
Unraveling Superbug Infections: Causes and Prevention Superbug

Unraveling the complex web of superbug infections delves into a critical aspect of modern healthcare. As we navigate the intricacies of microbial resistance, understanding the causes and fortifying preventive measures against these formidable adversaries becomes paramount. In this blog, we embark on a journey through the labyrinth of superbug infections, exploring their origins, the factors fueling their rise, and the crucial strategies pivotal in thwarting their spread. Join us as we uncover the hidden facets of this pressing issue, aiming to shed light on combating these resilient microscopic foes.
Read more about ofloxacin eye drops here.
What are Superbug?
Superbugs are resilient strains of bacteria, viruses, fungi, and other microorganisms that have developed resistance to commonly used antibiotics and medications. Their ability to withstand various treatments that were once effective makes them a considerable challenge in medical settings and the community at large.
The Rise of Superbug
The misuse and overuse of antibiotics in healthcare, agriculture, and even daily life have accelerated the evolution of these resistant organisms. Through natural selection, bacteria adapt to survive the onslaught of antibiotics, creating strains that are increasingly difficult to treat.

Causes of Superbug Infections
Overprescription of Antibiotics
Physicians prescribing antibiotics unnecessarily or inappropriately contribute significantly to the rise of superbugs. Patients often demand antibiotics for viral infections, which are unaffected by these medications, further exacerbating the problem.
Agricultural Practices
The agricultural sector’s use of antibiotics in livestock contributes to the development of resistant bacteria, which can spread through food consumption or environmental contamination.
Poor Infection Control
Inadequate hygiene practices in healthcare settings facilitate the spread of superbugs. Improper handwashing, lax sanitation measures, and insufficient sterilization of medical equipment create breeding grounds for these resilient microbes.
The Impact of Superbug Infections
Superbug infections can have severe consequences. They prolong illnesses, complicate treatments, increase healthcare costs, and in extreme cases, lead to fatalities. Diseases that were once easily treatable may become life-threatening due to antibiotic resistance.
Prevention Strategies
Responsible Antibiotic Use
Educating both healthcare professionals and the public about the appropriate use of antibiotics is paramount. Encouraging adherence to prescribed doses and avoiding self-medication can slow down the development of resistant strains.
Enhanced Hygiene Practices
Implementing rigorous hygiene protocols in hospitals and other healthcare facilities is crucial. Regular handwashing, stringent sterilization techniques, and proper waste disposal can mitigate the spread of superbugs.
Research and Development
Investment in research for new antibiotics and alternative treatments is vital in combating superbug infections. Developing innovative strategies to target resistant microbes while minimizing the emergence of new resistant strains is imperative.
The Future Battle Against Superbugs
The fight against superbugs is an ongoing battle that requires a collaborative effort on a global scale. Governments, healthcare providers, pharmaceutical companies, and individuals must work together to address this growing threat.
Collaboration and Awareness
International cooperation in monitoring and controlling the spread of superbugs is essential. Additionally, raising public awareness about the dangers of antibiotic resistance fosters a sense of responsibility in curbing its progression.
Innovation and Adaptation
Adopting new technologies and approaches in healthcare can revolutionize the way we combat superbugs. From advanced diagnostic tools to personalized medicine, innovation plays a pivotal role in staying ahead of evolving microbial threats.
Conclusion
The battle against superbug infections stands as a testament to the resilience of medical science and collective human efforts. As we conclude our exploration into the intricate world of superbugs, it’s evident that a multifaceted approach is imperative in safeguarding public health. By acknowledging the causes, advocating responsible antibiotic use, fortifying hygiene practices, and fostering innovation, we pave the way for a future where the menace of superbugs is mitigated. Let us continue to work hand in hand, fostering global collaboration, raising awareness, and embracing advancements in healthcare to ensure a world where superbug infections are controlled, allowing humanity to thrive in a healthier, more secure tomorrow.